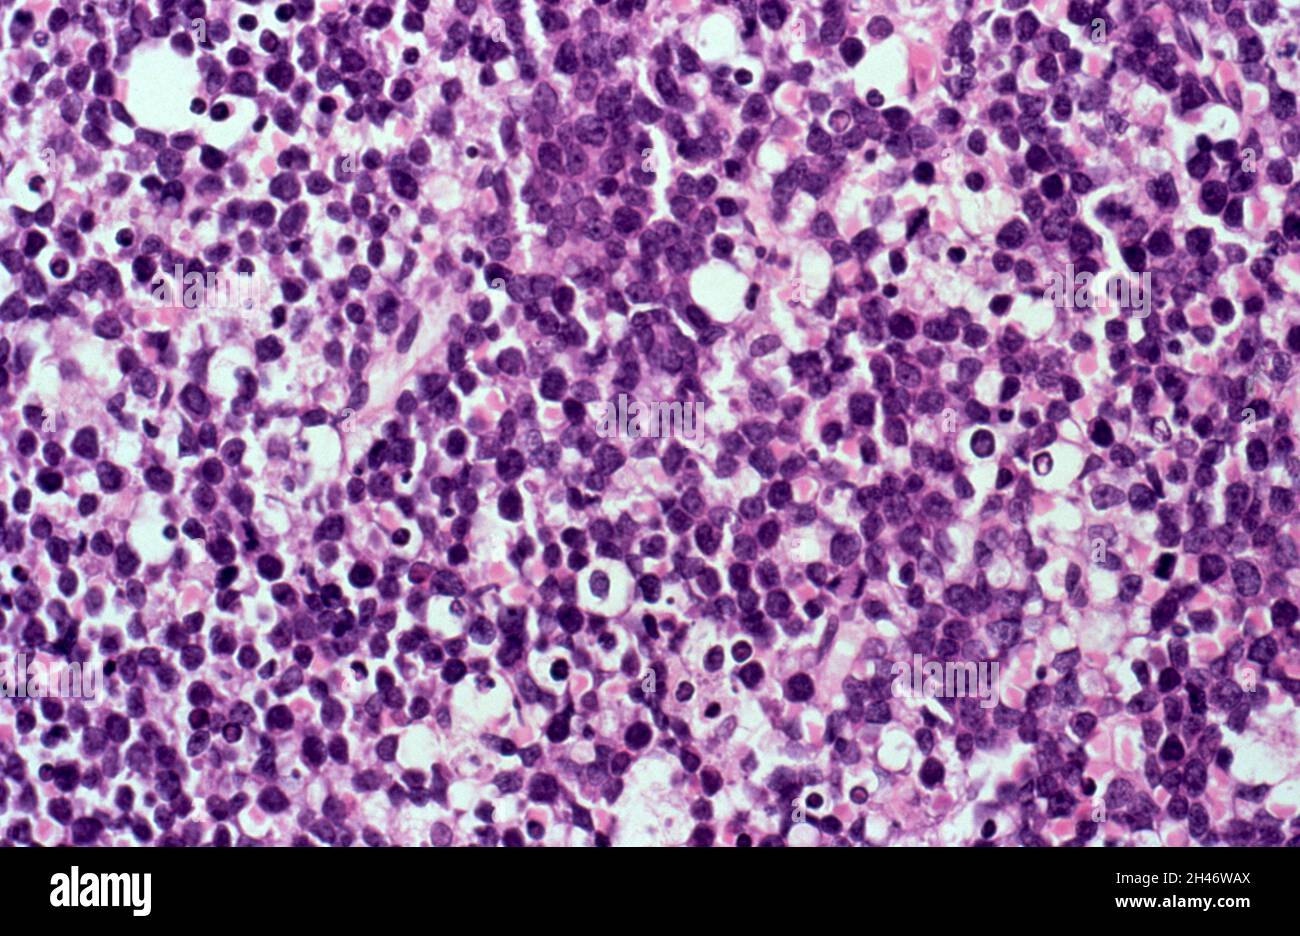
Lymphome non hodgkinien avec SIDA : moelle osseuse Banque D'Images

Bone marrow cross section Photos Stock & Des Images
(126)Filtres rapides :
Bone marrow cross section Photos Stock & Des Images

RF2K2KG8M–Coupe transversale d'un os humain montrant la moelle osseuse, l'os spongieux et les vaisseaux sanguins. 3D illustration

RF3CK9W9F–Coupe transversale d'un fémur humain avec gros plans de sa structure interne. Illustration numérique.

RMAX3BFN–Agatized os de dinosaure Allosaur cross section montre la moelle épinière de fémur Amethyst Crystal Jurassique centres Utah

RF2BMA0FA–Coupe transversale d'un os humain montrant la moelle osseuse, l'os spongieux et les vaisseaux sanguins. Illustration 3D.

RF2WNK325–Anatomie osseuse. Structure d'un fémur. Gros plan d'une coupe transversale de tissu osseux spongieux Trabéculé avec moelle osseuse rouge. illustration vectorielle

RF2R0MWDJ–Myélome multiple. Partie d'une colonne vertébrale avec section transversale d'une vertèbre avec structure osseuse et moelle osseuse. Gros plan des cellules plasmatiques anormales,

RF2MNGKXA–Myélome multiple. Les cellules du myélome dans la moelle osseuse produisent des immunoglobulines, ce qui entraîne des taux anormalement élevés d'anticorps dans le sang. Coupe transversale

RFPR1RMJ–Le tissu osseux. Couleur de l'analyse des électrons Microphotographie (SEM) de l'os spongieux (spongieux). Le tissu osseux peut être soit corticales (compact) ou d'os spongieux. L'os cortical fait généralement de l'extérieur de l'os, tandis que l'os spongieux se trouve dans l'intérieur. L'os spongieux se caractérise par un nid d'arrangement, comprenant un réseau de trabécules (forme de tige tissu). Ces structures offrent l'appui et la force de l'os. Les espaces au sein de ces tissus contiennent de la moelle osseuse (pas vu), une substance formant le sang. Grossissement : x13 lors de l'impression de 10 cm de largeur.

RF2YFF64M–Anatomie osseuse. Gros plan de l'ostéoclaste pour décomposer le tissu osseux, l'ostéoblaste qui synthétisent l'os et l'ostéocyte. Coupe transversale d'un fémur humain. Vecto

RF2YC9E6F–Moelle osseuse de boeuf frais tranchée en supemarket. Produit de l'industrie de la viande.

RF2WNN4GX–Anémie aplasique. Section transversale d'un fémur avec insuffisance médullaire. Gros plan d'une cellule sanguine. Les cellules souches de la moelle osseuse produisent des globules rouges,

RF2X9XB57–Anatomie osseuse. Gros plan des os compacts et spongieux. Structure fémorale. Moelle jaune et moelle osseuse rouge. Illustration vectorielle

RF2NEPJYK–OS de moelle de bœuf crus non cuits pour rôtir macro gros plan avec texture de graisse rouge rose sur plateau en plastique et personne comme nourriture à la mode

RMD0N10B–Coupe transversale d'un fémur montrant la structure anatomique dont l'os spongieux et la moelle.

RF3CK9W9J–Coupe transversale d'un fémur humain avec gros plans de sa structure interne. Illustration numérique.

RMAX3HBG–Agatized os de dinosaure - section Allosaur : affiche la moelle épinière de fémur - Amethyst Crystal centres - Late Jurassic - Utah

RF2BMA0F9–Coupe transversale d'un os humain montrant la moelle osseuse, l'os spongieux et les vaisseaux sanguins. Illustration 3D.

RFDT654W–Illustration détaillée d'un os, une section transversale, montrant la structure du matériel osseux et les espaces entre ses éléments.

RFPR1RKN–Le tissu osseux. Couleur de l'analyse des électrons Microphotographie (SEM) de l'os spongieux (spongieux). Le tissu osseux peut être soit corticales (compact) ou d'os spongieux. L'os cortical fait généralement de l'extérieur de l'os, tandis que l'os spongieux se trouve dans l'intérieur. L'os spongieux se caractérise par un nid d'arrangement, comprenant un réseau de trabécules (forme de tige tissu). Ces structures offrent l'appui et la force de l'os. Les espaces au sein de ces tissus contiennent de la moelle osseuse (pas vu), une substance formant le sang. Grossissement : x13 lors de l'impression de 10 cm de largeur.

RMCF7AT2–Retour allumé coupe transversale de moelle osseuse avec des graines séchées contre la lumière

RMD0MYG9–Coupe transversale d'un fémur montrant la structure anatomique dont l'os spongieux et la moelle.

RMAX3B8H–Agatized os de dinosaure Allosaur cross section montre la moelle épinière de fémur Amethyst Crystal Jurassique centres Utah

RF2GM87C0–Tissu osseux endommagé par l'ostéoporose, par rapport aux os sains humains. Structure spongieuse du squelette normale et éclaircie, illustration vectorielle

RFPR1RM9–Le tissu osseux. Couleur de l'analyse des électrons Microphotographie (SEM) de l'os spongieux (spongieux). Le tissu osseux peut être soit corticales (compact) ou d'os spongieux. L'os cortical fait généralement de l'extérieur de l'os, tandis que l'os spongieux se trouve dans l'intérieur. L'os spongieux se caractérise par un nid d'arrangement, comprenant un réseau de trabécules (forme de tige tissu). Ces structures offrent l'appui et la force de l'os. Les espaces au sein de ces tissus contiennent de la moelle osseuse (pas vu), une substance formant le sang. Grossissement : x13 lors de l'impression de 10 cm de largeur.

RF3CKPNX0–Coupe transversale de l'os humain montrant de la moelle, des globules rouges, des globules blancs et des plaquettes

RFFXP665–Le tissu osseux. Couleur de l'analyse des électrons Microphotographie (SEM) d'os spongieux (spongieux) os. Le tissu osseux peut être soit corticales (compact) ou d'os spongieux. L'os cortical fait généralement de l'extérieur de l'os, tandis que l'os spongieux se trouve dans l'intérieur. L'os spongieux se caractérise par un nid d'arrangement, comprenant un réseau de trabécules (forme de tige tissu). Ces structures offrent l'appui et la force de l'os. Les espaces au sein de ces tissus contiennent de la moelle osseuse (pas vu), une substance formant le sang. Grossissement : x40 lors de l'impression de 10 cm de largeur.

RMCF7B1D–Retour allumé coupe transversale de moelle osseuse avec des graines séchées contre la lumière

RMD0MWTM–Coupe transversale d'un fémur montrant la structure anatomique dont l'os spongieux et la moelle.

RF3BGD9XR–Milan, Italie 1er janvier 2025 : viande crue osso buco assaisonnée au romarin prête à être cuite

RMAX40WR–Agatized os de dinosaure - section Allosaur : affiche la moelle épinière de fémur - Amethyst Crystal centres - Late Jurassic - Utah

RM2CHM0TM–. Un texte-livre de physiologie comparative pour les étudiants et les praticiens de la médecine comparative (vétérinaire) . vertical cross - section présente la lamelle? Dont il est composé et les canaux vasculaires coupés(Fig. 445). Tout ceci est, cependant, seulement le cadre de tissu osseux.si un os d'un animal fraîchement tué, sans saignement, beexaminé, un état très différent des choses sera trouvé. Le médullaire est plus lourd; sa surface est recouverte d'une structure fibreuse très adhérente, dure, le périoste : et sa médullarycavité remplie de moelle. Si l'os est brisé, itssection

RF2BGA7M6–Leucocytes de limbo dans la moelle osseuse. Dépérissement des leucocytes dans la rate, le foie et aux sites d'inflammation. La vie des leucocytes.

RF2K58WT8–os de moelle de veau rôti ou os de boeuf du four pour la préparation du bouillon ou de la sauce

RMPFE5JT–. Der Aufbau der Skeletteile in den freien Gliedmassen der Wirbeltiere Untersuchungen ; un urodelen amphibien. . Fig. 114-116. Salamandra maculosa, stade II, tibia, Querschnitt aus einer Serie, schémas. Vergr. 55:1. Stades ist eine grosse. Knorpelige kommt die Grundlage dem größten Teil des Skelettstückes zu, sie aber fehlt fast völlig dans quelques Schnitten, die der Mitte der diaphyse. entsprechen. Der großblasige Diaphysenknorpel, une arme Grundsubstanz hier ist durch einen kleinen ersetzt rundlichen Markraum, welcher nur noch auf einem von Kuorpelstreifen schmalen umgeben wird.

RF3D21H7Y–Diagramme vectoriel détaillé de l'anatomie osseuse humaine, montrant la moelle, les vaisseaux sanguins et les types de cellules

RFFXP663–Le tissu osseux. Couleur de l'analyse des électrons Microphotographie (SEM) d'os spongieux (spongieux) os. Le tissu osseux peut être soit corticales (compact) ou d'os spongieux. L'os cortical fait généralement de l'extérieur de l'os, tandis que l'os spongieux se trouve dans l'intérieur. L'os spongieux se caractérise par un nid d'arrangement, comprenant un réseau de trabécules (forme de tige tissu). Ces structures offrent l'appui et la force de l'os. Les espaces au sein de ces tissus contiennent de la moelle osseuse (pas vu), une substance formant le sang. Grossissement : x40 lors de l'impression de 10 cm de largeur.

RMMCMWHK–. Fig. 43. Fipr. 44. Fig. 43. Schnitt (Fournirblatt) durch das obere Ende des Pemur noch nicht von ausgewachsenen (15jährigen) Individuums männlichen. Plmtiigrapliische Abhildunt^ : nach J. Wulff. Fig. 44. Sehematisirte figure der Architektur des oberen fémur- l'endes. Nach H. C. Meyer (1867). der beiden Seiten, wo sie in Ihrem Verlaufe rechtem einander schneiden, unter Winkel. Die zwischen ihnen gelegenen, von Knochen rothem- mark ausgefüllten Räume sind daher mehr oder quadratisch minder. Mit den Augen des ingénieurs betrachtet stellen, die von der , Druckbälkchen oder Druck- dans die en s

RMCF7AWA–Retour allumé coupe transversale de moelle osseuse avec des graines séchées contre la lumière

RMD0N0G7–Coupe transversale d'un fémur montrant la structure anatomique dont l'os spongieux et la moelle.

RMAX2XBG–Agatized os de dinosaure Allosaur cross section montre la moelle épinière de fémur Amethyst Crystal Jurassique centres Utah

RM2AJBNBB–Un manuel de référence de la médecine qui englobe l'ensemble des connaissances scientifiques et pratiques de la médecine et sciences connexes . Fig. 521,5.-Coupe transversale de la partie basale de l'IHE Clou d'un adulte.Modèle endurcis dans Muellers fluide et colorées avec hiema toxvlin-et-éosine. Diamètres 25 agrandie. (Après rabl.j F.Épiderme de mur de l'IHE uail (ALC), Ep. eponychium, N,nail ; .V, matrice de l'ongle : L, longimdinal frontière de la matri.v;yti., lit de l'ongle ; P, perlo.steum : K, l'os ;. ETjh, moelle osseuse. et est remplacé par de nouveaux cheveux. Cette régénération de thehair sur le foetus est continu

RF2K58WX2–os de moelle de veau rôti ou os de boeuf du four pour la préparation du bouillon ou de la sauce

RF3CKPHXJ–Illustration vectorielle détaillée de l'anatomie de la moelle osseuse, des types de cellules sanguines et de la structure vasculaire dans l'os

RMRHK64Y–. La biologie de la grenouille. Les grenouilles. Histologie DE LA GRENOUILLE 131 en faisant une section transversale du fémur. La partie centrale de l'os est creux et rempli de moelle osseuse, et la surface extérieure est recouverte d'une couche de périoste, qui est similaire à la structure de l'perichondrium entourant le cartilage. La substance osseuse est organisé en couches concentriques, ou lamellce lacunce, qui contiennent de nombreuses, dans laquelle se trouvent les cellules osseuses. Les lacunes de la ramification fine tubes, ou les processus de canalicules, contenant les cellules osseuses, sont libérés ex- tendent dans toutes les directions et s'anastomosent avec les canali

RF2K20XMK–os de moelle de veau rôti ou os de boeuf du four pour la préparation du bouillon ou de la sauce

RF3D0DCJ1–Illustration vectorielle de l'anatomie de la moelle osseuse, montrant les globules rouges, les globules blancs et les plaquettes

RMRHK7JJ–. La biologie de la grenouille. Les grenouilles. Histologie DE LA GRENOUILLE 127. .^^^ ^Im. os compact, qui est très ferme et dense, et l'os spongieux ou spongieux, qui est constitué de plaques et barres formant une structure qui est relativement lâche et manque de force. Ce dernier se trouve dans le centre de la verte- brae et dans une faible mesure à l'intérieur de certains des os longs. Un bon exemple de l'os compact peut être obtenu en faisant une section transversale de la fe- mur. La partie centrale de l'os est creux et rempli de moelle osseuse, et la surface extérieure est recouverte d'une couche de perioste- um, qui est simi- '^ ^'&

RF2HPRYD5–Grande moelle osseuse de boeuf hachée sur la moitié avec des épices et des herbes sur la souche en bois

RMRR2845–. Biologie avancée. Biologie ; physiologie ; la reproduction. .Cartal b-périoste de l'os en coupe agrandie montrant l'arrangement des cellules et des canaux par lesquels les vaisseaux sanguins s'exécuter. Le revêtement extérieur, périoste, et le centre rempli de moelle osseuse peut être vu dans le schéma plus bas. Certaines cellules, cellules du cartilage, associés en paires. Ils déposent un épais, dur matériel extracellulaire appelé une matrice. le corps sera blessé. Lorsqu'un os est cassé, la nouvelle partie première de- velops que le cartilage et est remplacé, par la suite, par de vrais os. Le type de cartilage a étudié dans l'exercice de laboratoire est hya